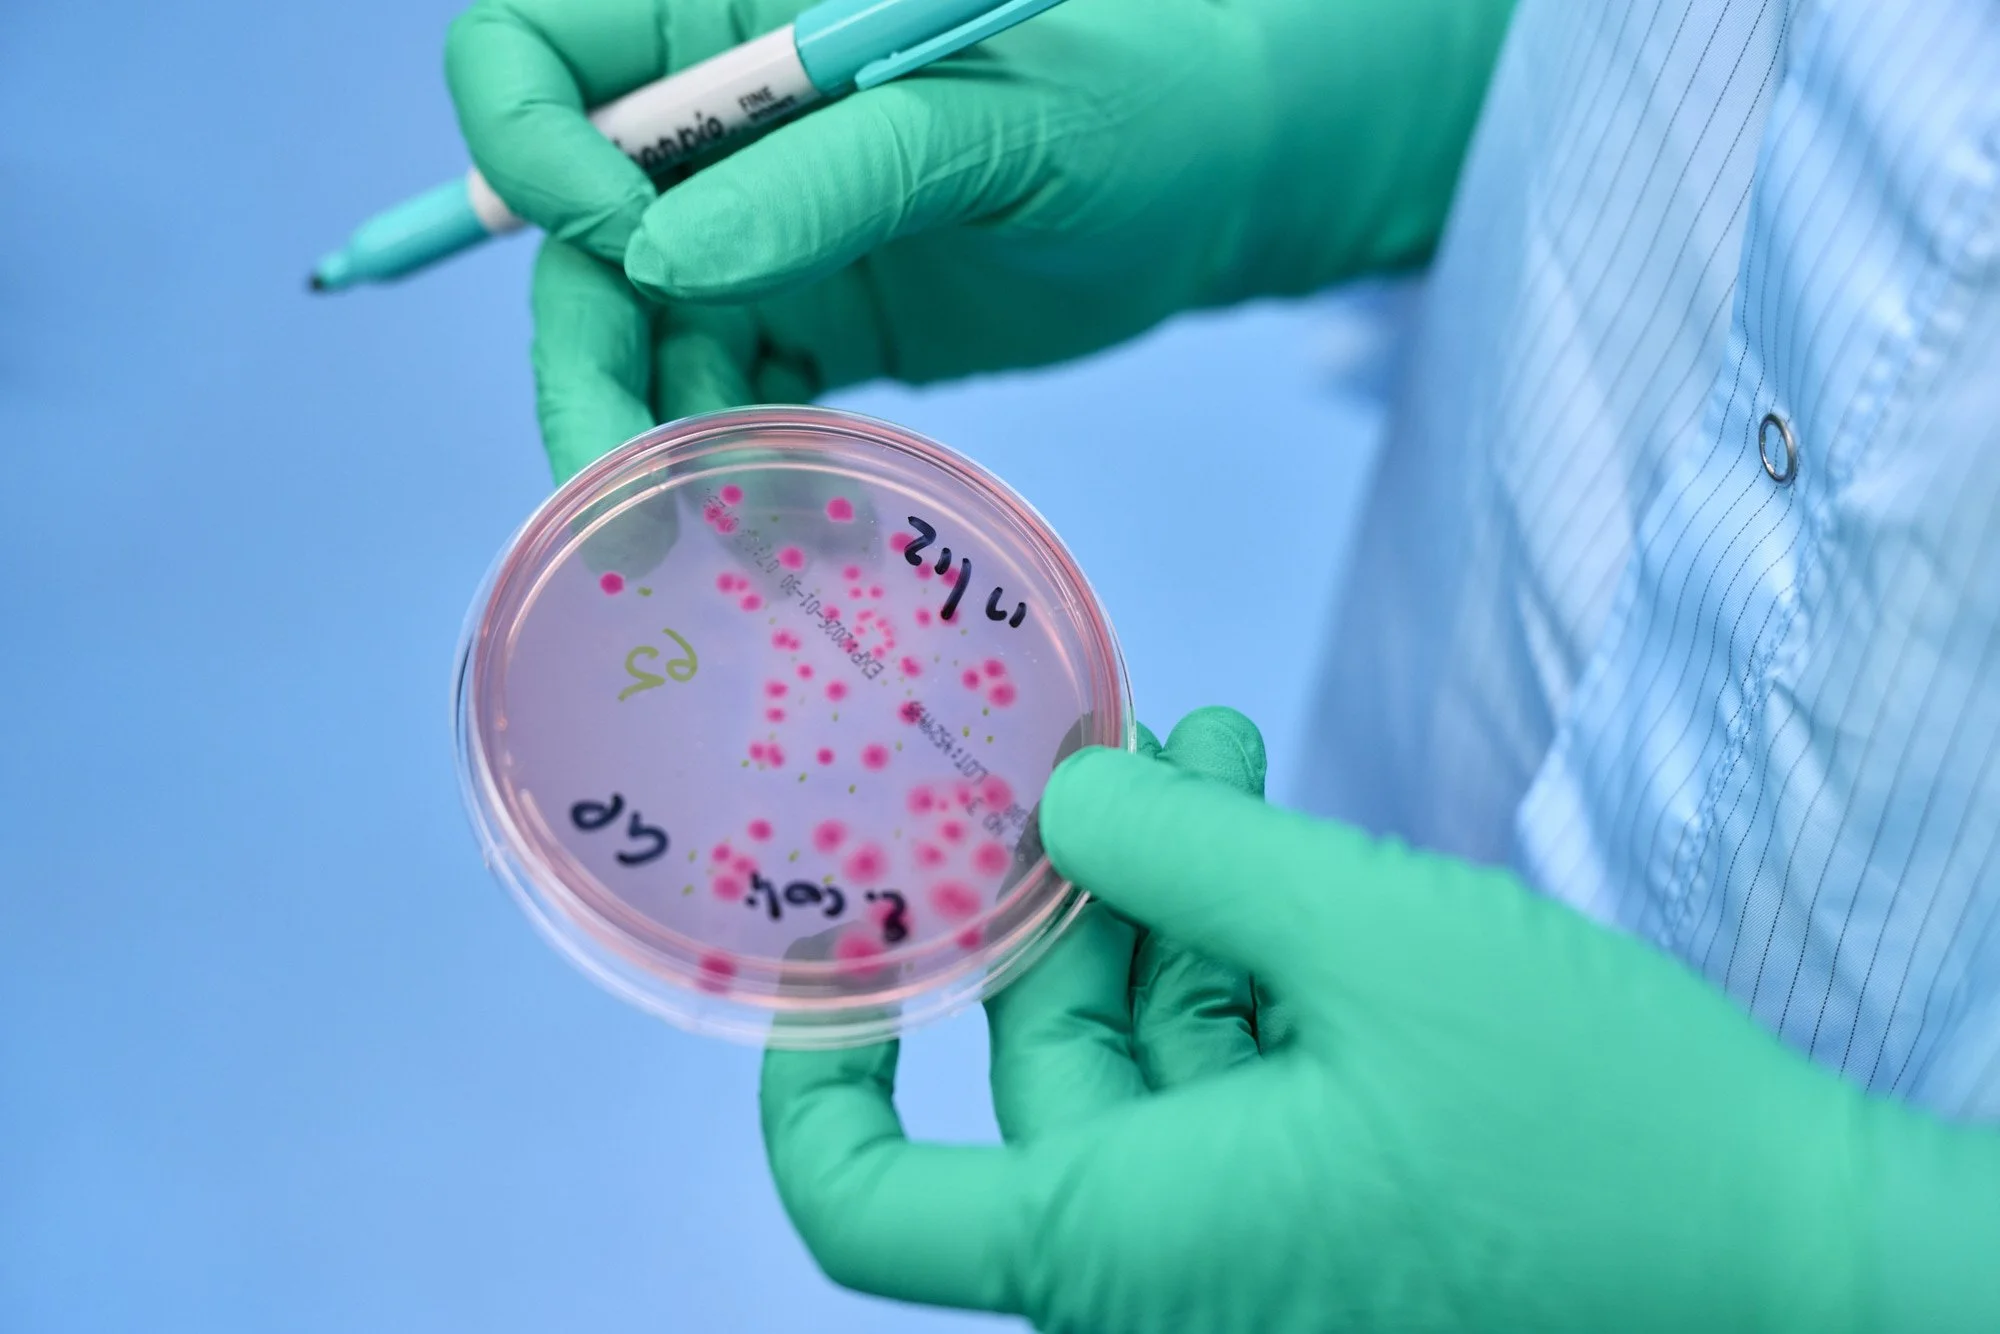

Microbiological Services
Robust microbiological testing is essential to ensuring product safety, quality and compliance across the full development lifecycle.
Our accredited laboratory provides a comprehensive suite of microbiology services, delivering reliable testing supported by expert microbiologists and validated methods.
We offer sterility testing, microbial limit testing, endotoxin analysis for raw materials, in‑process samples and finished products. Designed for early‑stage and small‑scale commercial needs, our microbiological services provide the flexibility and turnaround required to keep development or product to market moving.

Comprehensive sterility and safety testing
Robust bacterial endotoxin testing using recombinant factor C
Sterility testing of innovative devices
Complex microbial challenge method issues
Rapid ScanRDI sterility testing to accelerate release

Custom test method development and validation
Preservative efficacy testing of complex pharmaceutical products
Tests for microbial limits and specified organisms

Find out more

Sterile & low bioburden manufacture of liquid medicines
Fill and finish services
Download the Sample Analysis Form to submit your analysis request

